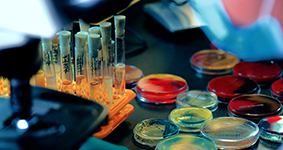

关于我们

微谱,大型研究型检测机构,始于2008年,总部位于上海,是科技服务改变世界的践行者
微谱聚焦先进制造、生物医药、美丽健康、生态环境、食品农产品五大领域,向社会提供分析测试、检测评价、研发服务、计量校准、认证审核、知识产权六大服务,全方位的技术解决方案助力客户取得更大成功。
微谱现已在全国30多个城市设立分子公司以及60多个专业实验室,拥有3000余名专业人员。
微谱始终秉承“服务,不止于检测!”的理念,尽心尽力让科技进步更快,让产品质量更好,让人类生活更安全、更健康、更绿色!

 高分子领域
高分子领域 精细化学品
精细化学品 化妆及消毒品
化妆及消毒品 环境检测
环境检测 生物医药
生物医药 金属领域
金属领域 食品领域
食品领域 热门行业
热门行业 我们的服务
我们的服务